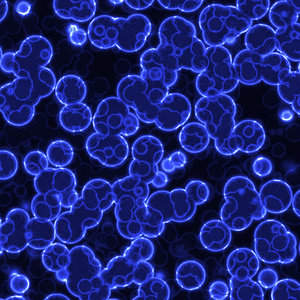
病毒扩散图片

颤蓝细菌

微生物馆_中国科普博览
图片尺寸326x397
2.几种蓝细菌:色球蓝细菌,颤蓝细菌,念珠蓝细菌 3.
图片尺寸260x380
蓝细菌-百科
图片尺寸300x237
丝藻&颤蓝细菌
图片尺寸1280x720
不要和外星人说话
图片尺寸754x754蓝细菌
图片尺寸1200x900
探索氧气起源奥秘蓝细菌触发地球大氧化事件
图片尺寸624x351
去火星开荒带什么好?
图片尺寸669x578
coli outbreak spreads as source of tainted let
图片尺寸920x624
头条文章
图片尺寸1080x1619
蓝细菌
图片尺寸324x400蓝细菌.
图片尺寸1100x1124
浙江林学院食品微生物学课件1.3ppt
图片尺寸1080x810
细菌培养皿图片
图片尺寸300x300
生命的开路先锋蓝细菌
图片尺寸450x286微生物
图片尺寸607x440
蓝细菌的五大类群
图片尺寸751x500
病毒扩散图片
图片尺寸300x300
蓝细菌能进行光合作用吗 爱问知识人
图片尺寸570x228
这些是2018年最佳微观世界动图想不到萌物还挺多
图片尺寸480x270